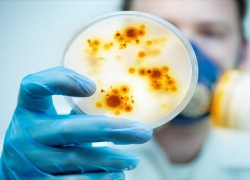
В Воронежской области на 20% понизилось количество инфекционных заболеваний

Общество
-
Борисоглебские поисковики уже несколько месяцев разыскивают, двоих пропавших мужчин
В Воронежской области продолжаются поиски 45-летнего борисоглебца Романа Пастушкова и 70-летнего жителя Грибановского района - Алексея Попова. Пропав...
Читать полностью...
 Об этом на брифинге рассказал глава областного избиркома, отметив отсутствие подозреваемых
В деле о фальсификации выборов 2016 года в Воронежской области до сих пор есть только свидетели
22.07.2018 08:20
Об этом на брифинге рассказал глава областного избиркома, отметив отсутствие подозреваемых
В деле о фальсификации выборов 2016 года в Воронежской области до сих пор есть только свидетели
22.07.2018 08:20
 «СД» ищет Алексея Попова и Романа Пастушкова
Борисоглебские поисковики уже несколько месяцев разыскивают, двоих пропавших мужчин
21.07.2018 18:30
«СД» ищет Алексея Попова и Романа Пастушкова
Борисоглебские поисковики уже несколько месяцев разыскивают, двоих пропавших мужчин
21.07.2018 18:30
 В самом центре города несколько последователей индуизма устроили ритуальное представление
Пляски кришнаитов у Воронежского облправительства попали на видео
21.07.2018 13:59
В самом центре города несколько последователей индуизма устроили ритуальное представление
Пляски кришнаитов у Воронежского облправительства попали на видео
21.07.2018 13:59
 Всего в Воронежской области родилось более 10 тыс. детей
С начала года в Борисоглебском городском округе на свет появилось 416 детей
21.07.2018 11:38
Всего в Воронежской области родилось более 10 тыс. детей
С начала года в Борисоглебском городском округе на свет появилось 416 детей
21.07.2018 11:38
 Можно не торопиться сдавать в утиль телевизоры, не принимающие цифровой сигнал
Борисоглебцы смогут смотреть местные телеканалы в аналоговом вещании и после 1-го января
21.07.2018 10:00
Можно не торопиться сдавать в утиль телевизоры, не принимающие цифровой сигнал
Борисоглебцы смогут смотреть местные телеканалы в аналоговом вещании и после 1-го января
21.07.2018 10:00
 За сутки два озера покрылись сине-зелёной плёнкой
Водоёмы в Новохоперском районе захватывают ядовитые водоросли
21.07.2018 09:10
За сутки два озера покрылись сине-зелёной плёнкой
Водоёмы в Новохоперском районе захватывают ядовитые водоросли
21.07.2018 09:10
 Женщина подделала свидетельства о рождении детей для получения маткапитала
Жительница Борисоглебска «родила» двоих детей с разницей в две с половиной недели
21.07.2018 08:20
Женщина подделала свидетельства о рождении детей для получения маткапитала
Жительница Борисоглебска «родила» двоих детей с разницей в две с половиной недели
21.07.2018 08:20
 После публикаций в СМИ, прокуратура проверила больницу и нашла массу нарушений
Владимир Коробов пообещал отремонтировать инфекционное отделение к сентябрю
20.07.2018 14:40
После публикаций в СМИ, прокуратура проверила больницу и нашла массу нарушений
Владимир Коробов пообещал отремонтировать инфекционное отделение к сентябрю
20.07.2018 14:40
 За назначение Александра Леонова депутаты райсовета проголосовали единогласно
Поворинские депутаты избрали и.о. главы администрации района
20.07.2018 13:10
За назначение Александра Леонова депутаты райсовета проголосовали единогласно
Поворинские депутаты избрали и.о. главы администрации района
20.07.2018 13:10
 Гусеву презентовали проект «Совершенствование системы медицинской помощи онкологическим больным»
В Воронежской области выявлено 65 тыс. человек, больных раком
20.07.2018 12:10
Гусеву презентовали проект «Совершенствование системы медицинской помощи онкологическим больным»
В Воронежской области выявлено 65 тыс. человек, больных раком
20.07.2018 12:10
 В Таловском районе педофил звонит детям, а в Рамонском – эксгибиционист разделся перед детьми
Детей в Воронежской области терроризируют педофилы и эксгибиционисты
20.07.2018 09:58
В Таловском районе педофил звонит детям, а в Рамонском – эксгибиционист разделся перед детьми
Детей в Воронежской области терроризируют педофилы и эксгибиционисты
20.07.2018 09:58
 Поклонская оказалось единственным депутатом «Единой России», проголосовавшим «против»
Наталье Поклонской грозит отставка за отказ поддержать пенсионную реформу
20.07.2018 08:50
Поклонская оказалось единственным депутатом «Единой России», проголосовавшим «против»
Наталье Поклонской грозит отставка за отказ поддержать пенсионную реформу
20.07.2018 08:50
 Аналитики из компании HeadHunter выяснили, какую работу ищут возрастные кандидаты
Кем хотят работать жители Воронежской области старше 50 лет
19.07.2018 17:10
Аналитики из компании HeadHunter выяснили, какую работу ищут возрастные кандидаты
Кем хотят работать жители Воронежской области старше 50 лет
19.07.2018 17:10
 «За» проголосовали 328 человек, «против» - 104
Госдума приняла законопроект о повышении пенсионного возраста
19.07.2018 16:16
«За» проголосовали 328 человек, «против» - 104
Госдума приняла законопроект о повышении пенсионного возраста
19.07.2018 16:16
 Работами представителя династии художников зрители смогут любоваться до конца сентября
В Борисоглебске открылась выставка Александра Бирюкова
19.07.2018 15:05
Работами представителя династии художников зрители смогут любоваться до конца сентября
В Борисоглебске открылась выставка Александра Бирюкова
19.07.2018 15:05
 Мера является временной и связана с проведением земляных работ
В Борисоглебске перекроют движение на двух перекрестках
19.07.2018 14:30
Мера является временной и связана с проведением земляных работ
В Борисоглебске перекроют движение на двух перекрестках
19.07.2018 14:30
 Специалисты усилили патрулирование
Опубликовано видео страшных последствий пожара в Воронежском заповеднике
19.07.2018 12:40
Специалисты усилили патрулирование
Опубликовано видео страшных последствий пожара в Воронежском заповеднике
19.07.2018 12:40
 Данная мера связана с переходом на новое программное обеспечение
Борисоглебский МФЦ временно приостановит прием документов по услугам Росреестра
19.07.2018 12:01
Данная мера связана с переходом на новое программное обеспечение
Борисоглебский МФЦ временно приостановит прием документов по услугам Росреестра
19.07.2018 12:01
 Ранее стационар дневного пребывания располагался в старой двухэтажке
В Поворино открыли стационар в железнодорожной поликлинике №4
19.07.2018 10:00
Ранее стационар дневного пребывания располагался в старой двухэтажке
В Поворино открыли стационар в железнодорожной поликлинике №4
19.07.2018 10:00
 Петиция была создана еще два года назад, но тогда она не была популярной
Россияне требуют назначить премьер-министру РФ зарплату, равную прожиточному минимуму
19.07.2018 09:25
Петиция была создана еще два года назад, но тогда она не была популярной
Россияне требуют назначить премьер-министру РФ зарплату, равную прожиточному минимуму
19.07.2018 09:25
 И о том, где можно купить знаменитые Третьяковские яйца
Каждый второй житель Борисоглебска гордится яйцами местного производителя
18.07.2018 18:32
И о том, где можно купить знаменитые Третьяковские яйца
Каждый второй житель Борисоглебска гордится яйцами местного производителя
18.07.2018 18:32
 Кабмин предложил очередную программу для облегчения трудоустройства постаревших работников
5 миллиардов рублей ежегодно власти обещают тратить на переобучение пожилых людей
18.07.2018 17:21
Кабмин предложил очередную программу для облегчения трудоустройства постаревших работников
5 миллиардов рублей ежегодно власти обещают тратить на переобучение пожилых людей
18.07.2018 17:21
 В том числе - 161 ребенок
В Воронежской области за полгода 230 человек переболели вшивостью
18.07.2018 16:20
В том числе - 161 ребенок
В Воронежской области за полгода 230 человек переболели вшивостью
18.07.2018 16:20
 Синоптики прогнозируют дожди, ветры и грозы
Желтый уровень опасности объявлен в Воронежской области
18.07.2018 15:30
Синоптики прогнозируют дожди, ветры и грозы
Желтый уровень опасности объявлен в Воронежской области
18.07.2018 15:30
 Это обусловлено ростом цен на продовольствие в потребительской корзине на 3,8%
Прожиточный минимум за второй квартал этого года будет увеличен на 4%
18.07.2018 15:00
Это обусловлено ростом цен на продовольствие в потребительской корзине на 3,8%
Прожиточный минимум за второй квартал этого года будет увеличен на 4%
18.07.2018 15:00
 Грибной сезон в Воронежской области начался отравлениями
Как не стать жертвой «тихой охоты»
18.07.2018 13:59
Грибной сезон в Воронежской области начался отравлениями
Как не стать жертвой «тихой охоты»
18.07.2018 13:59
 За смерть двух людей несовершеннолетнему грозит до 15 лет лишения свободы
17-летний воронежец, въехавший в толпу людей, не считает себя виновным
18.07.2018 12:27
За смерть двух людей несовершеннолетнему грозит до 15 лет лишения свободы
17-летний воронежец, въехавший в толпу людей, не считает себя виновным
18.07.2018 12:27
 Это на 40 млн. больше чем планировалось ранее
На лекарства для детей-инвалидов Воронежской области будет выделено 368,8 млн. рублей
18.07.2018 08:50
Это на 40 млн. больше чем планировалось ранее
На лекарства для детей-инвалидов Воронежской области будет выделено 368,8 млн. рублей
18.07.2018 08:50
 Сергей Чернышин: «…бояться не стоит, сразу под арест никого сажать не будут»
Жителям Воронежской области предлагают оставить свои отпечатки пальцев в базе МВД. На всякий случай
18.07.2018 08:10
Сергей Чернышин: «…бояться не стоит, сразу под арест никого сажать не будут»
Жителям Воронежской области предлагают оставить свои отпечатки пальцев в базе МВД. На всякий случай
18.07.2018 08:10
 При этом, водопроводная вода в регионе соответствует санитарным нормам
В Воронежской области продается худшая водка в России
17.07.2018 17:20
При этом, водопроводная вода в регионе соответствует санитарным нормам
В Воронежской области продается худшая водка в России
17.07.2018 17:20
 Наша героическая история
17 июля 1944 года по Садовому кольцу Москвы прошел «Парад побежденных»
17.07.2018 16:40
Наша героическая история
17 июля 1944 года по Садовому кольцу Москвы прошел «Парад побежденных»
17.07.2018 16:40
 Сильные осадки ожидаются уже сегодня вечером
МЧС объявило штормовое предупреждение из-за обильных дождей в Воронежской области
17.07.2018 15:30
Сильные осадки ожидаются уже сегодня вечером
МЧС объявило штормовое предупреждение из-за обильных дождей в Воронежской области
17.07.2018 15:30
 В порядке эксперимента курортный сбор ввели на восьми территориях региона
На Краснодарских курортах начали взимать налог с отдыхающих
17.07.2018 13:40
В порядке эксперимента курортный сбор ввели на восьми территориях региона
На Краснодарских курортах начали взимать налог с отдыхающих
17.07.2018 13:40
 «День живой воды и веселья» пройдет в Макашевке 21 июля
В ближайшие выходные борисоглебцев вновь ждет праздник на берегу Хопра
17.07.2018 13:00
«День живой воды и веселья» пройдет в Макашевке 21 июля
В ближайшие выходные борисоглебцев вновь ждет праздник на берегу Хопра
17.07.2018 13:00
 «Стратегия-2035» определит направления социально-экономического развития на ближайшие 17 лет
В Борисоглебске обсудили основополагающий документ развития округа
17.07.2018 12:14
«Стратегия-2035» определит направления социально-экономического развития на ближайшие 17 лет
В Борисоглебске обсудили основополагающий документ развития округа
17.07.2018 12:14
 Владельцы старых аналоговых телевизоров с 1 января 2019 года, не смогут смотреть большинство телепрограмм
Жителям Воронежской области помогут с переходом на цифровое вещание
17.07.2018 09:30
Владельцы старых аналоговых телевизоров с 1 января 2019 года, не смогут смотреть большинство телепрограмм
Жителям Воронежской области помогут с переходом на цифровое вещание
17.07.2018 09:30
 Заявки на участие подали 32 села региона
По каким критериям в Воронежской области выбирают самое красивое село
17.07.2018 08:50
Заявки на участие подали 32 села региона
По каким критериям в Воронежской области выбирают самое красивое село
17.07.2018 08:50
 300 противогазов жители села Липяги получили в подарок от правительства области в мае
Противогазы, подаренные жителям Терновского села, оказались неисправны
17.07.2018 08:10
300 противогазов жители села Липяги получили в подарок от правительства области в мае
Противогазы, подаренные жителям Терновского села, оказались неисправны
17.07.2018 08:10
 У села Макашевка гостей праздника развлекали мастер-классами и концертом
«День луговых цветов и трав» прошел на берегу Хопра в минувшую субботу
16.07.2018 18:00
У села Макашевка гостей праздника развлекали мастер-классами и концертом
«День луговых цветов и трав» прошел на берегу Хопра в минувшую субботу
16.07.2018 18:00
 Чтобы реализовать посадочный материал собственного производства, необходимо оформить документы
Жителей Воронежской области будут штрафовать за продажу семян и рассады
16.07.2018 17:20
Чтобы реализовать посадочный материал собственного производства, необходимо оформить документы
Жителей Воронежской области будут штрафовать за продажу семян и рассады
16.07.2018 17:20
 Книжная выставка-буккроссинг прошла под слоганом «Я люблю читать, а вы?»
«Библиодесант» высадился в центральном сквере Борисоглебска
16.07.2018 16:29
Книжная выставка-буккроссинг прошла под слоганом «Я люблю читать, а вы?»
«Библиодесант» высадился в центральном сквере Борисоглебска
16.07.2018 16:29
 В среднем родителям придётся выложить из своих карманов на 10 тыс. рублей больше чем в прошлом году
В вузах Воронежской области вырастет стоимость обучения
16.07.2018 14:30
В среднем родителям придётся выложить из своих карманов на 10 тыс. рублей больше чем в прошлом году
В вузах Воронежской области вырастет стоимость обучения
16.07.2018 14:30
 Жителей села поздравили артисты и гости праздника
Село Петровское под Борисоглебском отметило свой 265-й день рождения
16.07.2018 11:19
Жителей села поздравили артисты и гости праздника
Село Петровское под Борисоглебском отметило свой 265-й день рождения
16.07.2018 11:19
 Конкурс был приурочен к окончанию ЧМ-2018
«Блокнот Борисоглебск» и магазин «Антураж разыграли 2 подарочных сертификата и 25 памятных монет
16.07.2018 08:50
Конкурс был приурочен к окончанию ЧМ-2018
«Блокнот Борисоглебск» и магазин «Антураж разыграли 2 подарочных сертификата и 25 памятных монет
16.07.2018 08:50
 Гроза и дождь накроют регион
МЧС предупредило жителей Воронежской области о погодных катаклизмах
15.07.2018 15:12
Гроза и дождь накроют регион
МЧС предупредило жителей Воронежской области о погодных катаклизмах
15.07.2018 15:12
 Подписчица из Ростова-на-дону похвасталась приобретением
Борисоглебские Третьяки попали яйцами в международный паблик
15.07.2018 12:40
Подписчица из Ростова-на-дону похвасталась приобретением
Борисоглебские Третьяки попали яйцами в международный паблик
15.07.2018 12:40
 Изменения коснутся двух маршрутов
В июле изменится расписание поворинских электричек
15.07.2018 11:00
Изменения коснутся двух маршрутов
В июле изменится расписание поворинских электричек
15.07.2018 11:00
 Новые правила вступают в силу с сегодняшнего дня
Роспотребнадзор обязал производителей маркировать продукты с заменителями молочного жира
15.07.2018 10:00
Новые правила вступают в силу с сегодняшнего дня
Роспотребнадзор обязал производителей маркировать продукты с заменителями молочного жира
15.07.2018 10:00
 Тем, кто остаётся на лето в городе, приходится несладко
Как борисоглебцам пережить июльскую жару?
15.07.2018 09:20
Тем, кто остаётся на лето в городе, приходится несладко
Как борисоглебцам пережить июльскую жару?
15.07.2018 09:20
 Ситуации «не оказания помощи больному» возникают все чаще
Современная медицина. Больной скорее мертв, чем жив
15.07.2018 08:30
Ситуации «не оказания помощи больному» возникают все чаще
Современная медицина. Больной скорее мертв, чем жив
15.07.2018 08:30
О снижении заболеваемости проинформировал Роспотребнадзор
В Воронежской области на 20% понизилось количество инфекционных заболеваний
14.07.2018 17:20
О снижении заболеваемости проинформировал Роспотребнадзор
В Воронежской области на 20% понизилось количество инфекционных заболеваний
14.07.2018 17:20
 В прошлом году следователям поступило 6050 сообщений о подобных преступлениях
Цена ошибки – жизнь. СК РФ подготовил в Уголовный кодекс две новые статьи о врачебных ошибках
14.07.2018 16:30
В прошлом году следователям поступило 6050 сообщений о подобных преступлениях
Цена ошибки – жизнь. СК РФ подготовил в Уголовный кодекс две новые статьи о врачебных ошибках
14.07.2018 16:30
 Переплата при покупке в среднем составляет 17,5%
Даунсайзинг − обман потребителя, или почему мы платим больше за меньшее
14.07.2018 15:30
Переплата при покупке в среднем составляет 17,5%
Даунсайзинг − обман потребителя, или почему мы платим больше за меньшее
14.07.2018 15:30
 Увидеть астрономическое событие можно в ночь с субботы на воскресенье
На этих выходных борисоглебцев ожидает мини-парад планет
14.07.2018 13:30
Увидеть астрономическое событие можно в ночь с субботы на воскресенье
На этих выходных борисоглебцев ожидает мини-парад планет
14.07.2018 13:30
 Прокуратура Воронежской области опубликовала статистику за 6 месяцев 2018 года
Борисоглебский округ вошёл в «пятёрку» самых криминальных районов области
14.07.2018 12:09
Прокуратура Воронежской области опубликовала статистику за 6 месяцев 2018 года
Борисоглебский округ вошёл в «пятёрку» самых криминальных районов области
14.07.2018 12:09
 А до уровня средней зарплаты по региону не дотягивают более 80%
Каждый пятый житель Борисоглебска получает зарплату ниже МРОТ
14.07.2018 10:40
А до уровня средней зарплаты по региону не дотягивают более 80%
Каждый пятый житель Борисоглебска получает зарплату ниже МРОТ
14.07.2018 10:40
 Синоптики пообещали жаркую и дождливую погоду в Воронежской области
Борисоглебцев ожидают тропические выходные
14.07.2018 09:50
Синоптики пообещали жаркую и дождливую погоду в Воронежской области
Борисоглебцев ожидают тропические выходные
14.07.2018 09:50
 Ольга Губанова провела мастер-класс по изготовлению глиняной игрушки для детей и их родителей
Ребята из борисоглебского детского сада №11 приобщились к народному творчеству
14.07.2018 09:10
Ольга Губанова провела мастер-класс по изготовлению глиняной игрушки для детей и их родителей
Ребята из борисоглебского детского сада №11 приобщились к народному творчеству
14.07.2018 09:10
 Авиалесоохрана дала прогноз на выходные
Желтый и оранжевый уровни опасности объявили в Воронежской области
14.07.2018 08:20
Авиалесоохрана дала прогноз на выходные
Желтый и оранжевый уровни опасности объявили в Воронежской области
14.07.2018 08:20
 Участниками проекта станут «герои» «Колхозграда»
«Блокнот Борисоглебск» запускает «КолхозГрадШоу»
13.07.2018 17:51
Участниками проекта станут «герои» «Колхозграда»
«Блокнот Борисоглебск» запускает «КолхозГрадШоу»
13.07.2018 17:51
 Строительство одиннадцати ФОКов запланировано в Воронежской области
В Борисоглебском округе построят три новых ФОКа
13.07.2018 16:31
Строительство одиннадцати ФОКов запланировано в Воронежской области
В Борисоглебском округе построят три новых ФОКа
13.07.2018 16:31
 Запланировано снести шесть ветхих многоквартирных домов барачного типа
В Поворино начался снос нежилых аварийных строений
13.07.2018 16:21
Запланировано снести шесть ветхих многоквартирных домов барачного типа
В Поворино начался снос нежилых аварийных строений
13.07.2018 16:21
 Активисты ТОС «Ветер перемен» получили грант из областного бюджета
В Терновском районе общественники благоустроили парк за 1 млн. рублей
13.07.2018 14:00
Активисты ТОС «Ветер перемен» получили грант из областного бюджета
В Терновском районе общественники благоустроили парк за 1 млн. рублей
13.07.2018 14:00
 На сегодняшний день обеспечены жильём 4553 ветерана войны
В Воронежской области 99% ветеранов войны улучшили жилищные условия
13.07.2018 13:20
На сегодняшний день обеспечены жильём 4553 ветерана войны
В Воронежской области 99% ветеранов войны улучшили жилищные условия
13.07.2018 13:20
 На работы из областного бюджета было выделено 780 тыс. рублей
В селе Макашевка под Борисоглебском отремонтировали мемориал землякам-красноармейцам
13.07.2018 12:56
На работы из областного бюджета было выделено 780 тыс. рублей
В селе Макашевка под Борисоглебском отремонтировали мемориал землякам-красноармейцам
13.07.2018 12:56
 При этом за выплатами обратилось только 30% семей
С 1 января 2018 года в Воронежской области на свет появилось 4590 первенцев
13.07.2018 10:30
При этом за выплатами обратилось только 30% семей
С 1 января 2018 года в Воронежской области на свет появилось 4590 первенцев
13.07.2018 10:30
 Принять участие в акции можно до 31 июля 2018 года
«Ростелеком» сказал «Добро пожаловать» мобильным абонентам
13.07.2018 10:22
Принять участие в акции можно до 31 июля 2018 года
«Ростелеком» сказал «Добро пожаловать» мобильным абонентам
13.07.2018 10:22
 Новые правила бесплатного вылова рыбы частными лицами вступят в силу с 2019 года
В России со следующего года ограничат рыбалку с удочкой и спиннингом
13.07.2018 10:02
Новые правила бесплатного вылова рыбы частными лицами вступят в силу с 2019 года
В России со следующего года ограничат рыбалку с удочкой и спиннингом
13.07.2018 10:02
 Глава округа посетила Почетного гражданина Борисоглебска
Елена Агаева вручила Виктору Глотову нагрудный знак, выпущенный к 320-летию города
13.07.2018 08:50
Глава округа посетила Почетного гражданина Борисоглебска
Елена Агаева вручила Виктору Глотову нагрудный знак, выпущенный к 320-летию города
13.07.2018 08:50
 Чтобы каждый колокол имел свое звучание, баллоны обрезали на разную длину
В Грибановском районе прихожане соорудили церковные колокола из газовых баллонов
13.07.2018 08:10
Чтобы каждый колокол имел свое звучание, баллоны обрезали на разную длину
В Грибановском районе прихожане соорудили церковные колокола из газовых баллонов
13.07.2018 08:10
 Конкурс приурочен к окончанию Чемпионата мира по футболу
ВНИМАНИЕ, КОНКУРС! Победителей ждут сертификаты от магазина «Антураж», а 25 участников получат подарки
12.07.2018 17:40
Конкурс приурочен к окончанию Чемпионата мира по футболу
ВНИМАНИЕ, КОНКУРС! Победителей ждут сертификаты от магазина «Антураж», а 25 участников получат подарки
12.07.2018 17:40
 Праздник пройдет в Макашевке на берегу Хопра
Борисоглебцев приглашают на День луговых цветов и трав
12.07.2018 16:48
Праздник пройдет в Макашевке на берегу Хопра
Борисоглебцев приглашают на День луговых цветов и трав
12.07.2018 16:48
 Шестой сезон подряд в долине реки Елань проводит раскопки экспедиция студентов и преподавателей ВГУ
В Воронежской области археологами найдены уникальные древние захоронения
12.07.2018 15:25
Шестой сезон подряд в долине реки Елань проводит раскопки экспедиция студентов и преподавателей ВГУ
В Воронежской области археологами найдены уникальные древние захоронения
12.07.2018 15:25
 Статья предусматривает лишение свободы на срок до 2 лет
Поставка контрафактных бензопил в «Воронежский лесопожарный центр» закончилась уголовным делом
12.07.2018 13:27
Статья предусматривает лишение свободы на срок до 2 лет
Поставка контрафактных бензопил в «Воронежский лесопожарный центр» закончилась уголовным делом
12.07.2018 13:27
 Основная причина – сохранение пернатой дичи, а также пушных и копытных животных
В нескольких районах Воронежской области введут многолетний запрет на охоту
12.07.2018 11:00
Основная причина – сохранение пернатой дичи, а также пушных и копытных животных
В нескольких районах Воронежской области введут многолетний запрет на охоту
12.07.2018 11:00
 Прежний балаганный настрой Безменского и Житенева в этот момент буквально сошел на нет
Антиникелевым экоактивистам прокурор огласил срок
12.07.2018 10:10
Прежний балаганный настрой Безменского и Житенева в этот момент буквально сошел на нет
Антиникелевым экоактивистам прокурор огласил срок
12.07.2018 10:10
 Роман Боковой идет на повышение из Новохоперского района
В Грибановском районе назначили нового начальника отдела МВД
12.07.2018 09:30
Роман Боковой идет на повышение из Новохоперского района
В Грибановском районе назначили нового начальника отдела МВД
12.07.2018 09:30
 У автовладельцев может появиться возможность оформлять у дилеров регистрацию при покупке машины
Новый закон о регистрации автомобилей может не понравиться ГИБДД
12.07.2018 08:50
У автовладельцев может появиться возможность оформлять у дилеров регистрацию при покупке машины
Новый закон о регистрации автомобилей может не понравиться ГИБДД
12.07.2018 08:50
 Следить за новостями информационного портала стало еще проще
«Блокнот Борисоглебск» теперь и в «Instagram»
12.07.2018 08:10
Следить за новостями информационного портала стало еще проще
«Блокнот Борисоглебск» теперь и в «Instagram»
12.07.2018 08:10
 Экологический налог приведет к подорожанию табака, однако, чиновников это только радует
Минздрав вводит налог на дым и окурки
11.07.2018 17:10
Экологический налог приведет к подорожанию табака, однако, чиновников это только радует
Минздрав вводит налог на дым и окурки
11.07.2018 17:10
 А говорят, что жить стали дольше
На 58-м году жизни скончался внук генерального секретаря ЦК КПСС - Андрей Брежнев
11.07.2018 16:20
А говорят, что жить стали дольше
На 58-м году жизни скончался внук генерального секретаря ЦК КПСС - Андрей Брежнев
11.07.2018 16:20
 Для этого Правительство РФ выделило из своего бюджета 29 млн. рублей
Для модернизации медучреждений Воронежской области закупят около тысячи компьютеров
11.07.2018 15:40
Для этого Правительство РФ выделило из своего бюджета 29 млн. рублей
Для модернизации медучреждений Воронежской области закупят около тысячи компьютеров
11.07.2018 15:40
 Чтобы не подвергать риску свою жизнь и здоровье, важно выбрать правильное место отдыха
Где борисоглебцы и жители близлежащих районов могут безопасно искупаться
11.07.2018 15:00
Чтобы не подвергать риску свою жизнь и здоровье, важно выбрать правильное место отдыха
Где борисоглебцы и жители близлежащих районов могут безопасно искупаться
11.07.2018 15:00
 Инициативу внесли на рассмотрение депутаты от "Справедливой России"
Госдума и правительство одобрили законопроект об отмене роуминга
11.07.2018 14:30
Инициативу внесли на рассмотрение депутаты от "Справедливой России"
Госдума и правительство одобрили законопроект об отмене роуминга
11.07.2018 14:30
 Ведомство предлагает расширить их полномочия, чтобы бороться с незаконным предпринимательством
Федеральная налоговая служба тянет руки к банковским счетам физических лиц
11.07.2018 13:50
Ведомство предлагает расширить их полномочия, чтобы бороться с незаконным предпринимательством
Федеральная налоговая служба тянет руки к банковским счетам физических лиц
11.07.2018 13:50
 Для проведения ЕГЭ было задействовано 119 964 камеры
Система видеонаблюдения «Ростелекома» обеспечила 100% онлайн-трансляцию в период проведения ЕГЭ-2018
11.07.2018 13:19
Для проведения ЕГЭ было задействовано 119 964 камеры
Система видеонаблюдения «Ростелекома» обеспечила 100% онлайн-трансляцию в период проведения ЕГЭ-2018
11.07.2018 13:19
 51-летний полковник полиции Геннадий Копачёв может покинуть пост
Начальник Росгвардии по Воронежской области может не вернуться из отпуска
11.07.2018 13:05
51-летний полковник полиции Геннадий Копачёв может покинуть пост
Начальник Росгвардии по Воронежской области может не вернуться из отпуска
11.07.2018 13:05
 Проверка проводилась с целью подтверждения достоверности криминальной статистики
Прокуратура Воронежской области обнародовала итоги проверки правоохранительных органов
11.07.2018 12:59
Проверка проводилась с целью подтверждения достоверности криминальной статистики
Прокуратура Воронежской области обнародовала итоги проверки правоохранительных органов
11.07.2018 12:59
 Борисоглебских родителей призвали не оставлять детей без присмотра
За первое полугодие в Воронежской области погибло 22 ребенка
11.07.2018 10:15
Борисоглебских родителей призвали не оставлять детей без присмотра
За первое полугодие в Воронежской области погибло 22 ребенка
11.07.2018 10:15
 Мнения высказывались разные: от радикального неприятия реформы до оправдания ее неизбежности
Воронежские общественники обсудили перспективы пенсионной реформы
11.07.2018 08:10
Мнения высказывались разные: от радикального неприятия реформы до оправдания ее неизбежности
Воронежские общественники обсудили перспективы пенсионной реформы
11.07.2018 08:10
 Главной причиной гибели на водоёмах спасатели считают алкоголь
С начала июля в Воронежской области утонуло 16 человек
10.07.2018 18:21
Главной причиной гибели на водоёмах спасатели считают алкоголь
С начала июля в Воронежской области утонуло 16 человек
10.07.2018 18:21
 До конца августа члены конкурсной комиссии посетят эти места и проверят соответствие заявленного действительности
За звание самого красивого воронежского села поборются 32 населенных пункта
10.07.2018 16:50
До конца августа члены конкурсной комиссии посетят эти места и проверят соответствие заявленного действительности
За звание самого красивого воронежского села поборются 32 населенных пункта
10.07.2018 16:50
 Ими оказались двое молодых людей 19 и 20 лет
Подозреваемых в убийстве женщины-таксиста из Терновки тамбовчан задержали в Борисоглебске
10.07.2018 16:10
Ими оказались двое молодых людей 19 и 20 лет
Подозреваемых в убийстве женщины-таксиста из Терновки тамбовчан задержали в Борисоглебске
10.07.2018 16:10
 Новые наказания предлагает ввести Минэкономразвития
За езду без техосмотра − штраф, за незаконное проведение ТО - уголовная ответственность
10.07.2018 15:30
Новые наказания предлагает ввести Минэкономразвития
За езду без техосмотра − штраф, за незаконное проведение ТО - уголовная ответственность
10.07.2018 15:30
 За полгода показатель вырос на 3,4%
В Воронежской области выросло количество потенциальных банкротов
10.07.2018 14:40
За полгода показатель вырос на 3,4%
В Воронежской области выросло количество потенциальных банкротов
10.07.2018 14:40
 Открытое первенство пройдет в селе Пески
В Поворинском районе пройдут соревнования по рыбной ловле «На Медвежьем – 2018»
10.07.2018 11:20
Открытое первенство пройдет в селе Пески
В Поворинском районе пройдут соревнования по рыбной ловле «На Медвежьем – 2018»
10.07.2018 11:20





